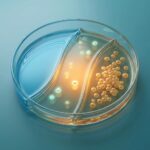
Grafic interpretare rezultate urocultura zona gri

Descoperă ce înseamnă urocultura și utilitatea ei

Te ustură? Simți nevoia să mergi la toaletă din 10 în 10 minute? Nu ești singur – infecțiile urinare sunt extrem de frecvente, dar vestea bună e că se tratează ușor dacă sunt diagnosticate corect. Urocultura este „cheia” care îi spune medicului exact ce bacterie îți face probleme și, mai important, cu ce antibiotic o poți elimina definitiv. Fără ea, tratamentul e doar o ghicitoare periculoasă.
📋 Cuprins: Ce vei afla
Ce înseamnă, de fapt, urocultura?
Termenul poate suna medical și complicat, dar conceptul este simplu. Gândește-te la urocultură ca la o „grădinărit” microscopic. În laborator, specialiștii iau o mică mostră din urina ta și o pun într-un mediu nutritiv special (ca un sol fertil), la o temperatură caldă.
Dacă în urină există bacterii (microbi), acestea se vor simți ca acasă și vor începe să se înmulțească, formând colonii vizibile. Dacă urina este sterilă (curată), nu va crește nimic.
💡 Știai că? Urina este, în mod normal, un lichid steril. Nu ar trebui să conțină bacterii, viruși sau ciuperci. Prezența lor indică, de cele mai multe ori, o infecție.
De ce nu ajung doar simptomele?
Poți avea simptome de cistită (usturime, nevoie deasă de urinare) dar să nu fie o infecție bacteriană, ci o iritație. Sau poți avea o infecție cu o bacterie rară, rezistentă la antibioticele obișnuite. Aici intervine antibiograma.
Odată ce bacteriile au crescut, laborantul le testează cu diferite tipuri de antibiotice pentru a vedea care dintre ele le distruge cel mai eficient. Așa primești tratamentul „țintit”, care te vindecă repede și nu îți distruge flora intestinală degeaba.

Când se recomandă urocultura? (Semne de alarmă)
Nu trebuie să faci această analiză săptămânal, dar există momente cheie când medicul o va solicita obligatoriu. Dacă te regăsești în una dintre situațiile de mai jos, s-ar putea să ai nevoie de un recipient steril:
- 🔥 Usturime sau durere persistentă la urinare (disurie).
- 🚽 Polakiurie: Nevoia de a merge la baie foarte des, chiar dacă elimini doar câteva picături.
- 🩸 Hematurie: Urină roșiatică sau cu urme vizibile de sânge (Urgență!).
- 🤢 Urină tulbure sau cu un miros neobișnuit, foarte puternic (amoniacal).
- 🌡️ Febră și frisoane inexplicabile, însoțite de durere de spate (zona lombară).
Ghid complet de recoltare: Cum eviți greșelile?
Un rezultat corect depinde 90% de cum recoltezi proba. O greșeală mică (cum ar fi atingerea interiorului capacului) poate contamina proba cu bacterii de pe mâini, ducând la un rezultat fals pozitiv și tratament inutil.

Regula de aur: „Jetul Mijlociu”
De ce toți medicii insistă cu „jetul mijlociu”? Simplu: primul jet de urină spală uretra și spală bacteriile care se află natural la intrarea în ea. Acele bacterii nu sunt din vezică, deci nu ne interesează. Noi vrem să analizăm urina din vezică.
- Lasă primul jet să curgă în toaletă (aprox. 2-3 secunde).
- Fără a opri fluxul (pe cât posibil), plasează recipientul sub jet.
- Colectează aproximativ 20-50ml de urină.
- Retrage recipientul înainte de a termina urinarea.
Urmărește acest video scurt care explică vizual procedura corectă:
Urocultura vs. Sumar de urină: Care e diferența?
Multă lume le confundă, dar sunt analize diferite care se completează reciproc.
| Caracteristică | Sumar de Urină | Urocultură |
|---|---|---|
| Ce măsoară? | Proprietăți fizico-chimice (pH, densitate, glucoză, proteine). | Identifică BACTERIILE specifice și numărul lor. |
| Timp rezultat | Rapid (câteva ore sau pe loc cu dipstick). | Lent (3-5 zile) – bacteriile au nevoie de timp să crească. |
| Scop principal | Screening general, diabet, boli renale, suspiciune infecție. | CONFIRMAREA infecției și găsirea antibioticului (Antibiograma). |
8 Scenarii concrete: Tu în care te regăsești?
🤰 1. În sarcină
Obligatorie în trimestrul I, chiar fără simptome. O infecție netratată poate declanșa naștere prematură. Medicul o verifică lunar.
👶 2. La bebeluși
Febra fără altă cauză (fără roșu în gât, fără tuse) este adesea semn de infecție urinară. Se folosesc pungi colectoare speciale.
👴 3. Bărbați peste 50 de ani
Infecțiile sunt rare la bărbații tineri. După 50 de ani, ele pot semnala probleme cu prostata (adenom) care blochează fluxul urinar.
🔄 4. Infecții Recurente
Dacă faci cistită de 3 ori pe an, urocultura cu antibiogramă este crucială. Poate bacteria ta e rezistentă la antibioticul uzual.
🏥 5. Înainte de operații
Orice operație urologică necesită urină sterilă. Altfel, bacteria poate intra în sânge în timpul intervenției (sepsis).
💊 6. După tratament
Urocultura de control se face la 7-10 zile după terminarea antibioticului, pentru a confirma că bacteria a dispărut complet.
🥶 7. „M-a tras curentul”
Frigul scade imunitatea locală, dar NU cauzează infecția. Tot o bacterie e de vină, iar urocultura o va găsi.
🎒 8. La intrarea în colectivitate
Grădinițele cer adesea „aviz epidemiologic”. Deși sumarul e standard, uneori se cere și urocultura pentru a depista purtătorii asimptomatici.

Cum citim rezultatele (Pe scurt)
Rezultatul vine sub formă de cifre, măsurate în UFC/ml (Unități Formatoare de Colonii pe mililitru). E important să nu intri în panică dacă vezi cifre, ci să verifici pragurile.
⚠️ Ai primit rezultatul 1000 UFC/ml sau „Flora polimorfă”?
Aceste rezultate sunt adesea confuze. Nu înseamnă neapărat infecție, dar nici că ești perfect sănătos. Am scris un ghid complet dedicat interpretării acestor valori „de graniță”.
- Negativ (Steril): < 1.000 UFC/ml. Ești bine, nu ai infecție.
- Pozitiv (Infecție): > 100.000 UFC/ml. Necesită antibiotic conform antibiogramei.
- Incert: Între 1.000 și 100.000. Poate fi o infecție la început sau o contaminare a probei (nu te-ai spălat bine). Adesea se repetă analiza.
Întrebări Frecvente despre Urocultură
Cât costă o urocultură în 2026?
Cât durează rezultatul?
Pot face urocultura dacă sunt la menstruație?
Trebuie să nu mănânc înainte?
Ce înseamnă E. Coli în urină?
Pot lua antibiotice înainte de analiză?
🌿 Aliați naturali pentru sănătatea urinară
Pe lângă tratamentul prescris de medic, suplimentele pe bază de merișoare sau albastru de metilen pot ajuta la prevenirea recidivelor.
- ✅ Urinal Akut: Concentrat de merișor canadian – Verifică preț aici
- ✅ Uractiv: Combinație clasică pentru confort urinar – Vezi oferte Farmacia Tei
*Discutați întotdeauna cu medicul înainte de a lua suplimente. Link-urile pot fi afiliate.
💭 Tu ai avut vreodată un rezultat confuz la urocultură?
Spune-ne în comentarii dacă ai reușit să scapi de infecțiile recurente și ce a funcționat pentru tine!
📖 Referințe și surse de încredere
- Synevo România – Ghid de recoltare
- MedLife – Interpretare analize urologie
- Asociația Europeană de Urologie (EAU Guidelines on Urological Infections)